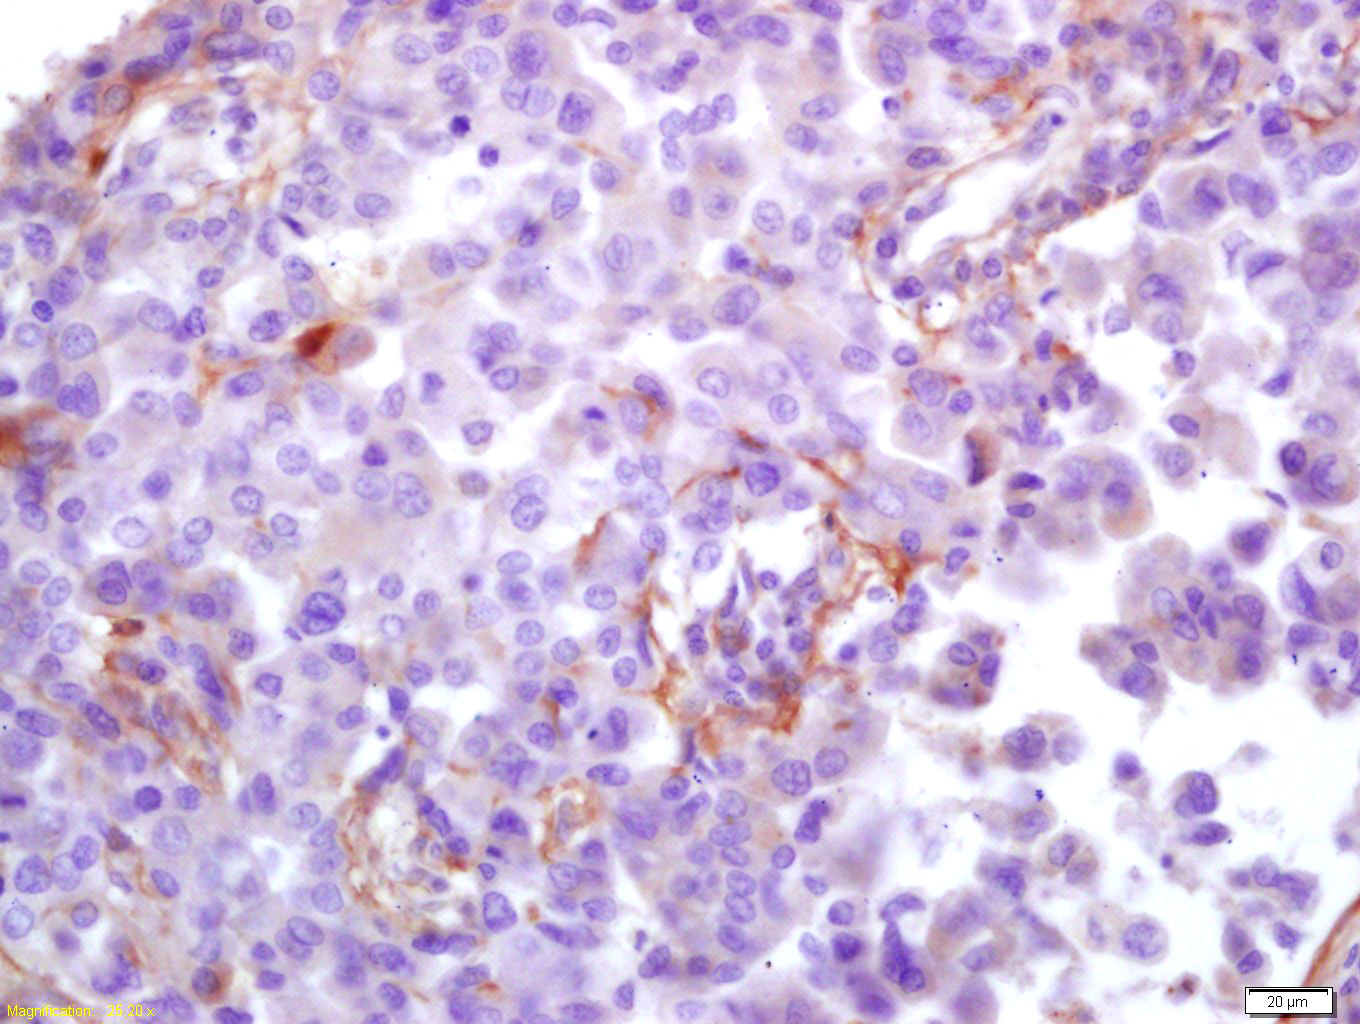
产品细节图片1

相关产品推荐更多 >

phospho-AKT1 (Ser473 + Tyr474) Rabbit pAb, APC-Cy5.5 conjugated(bs-10134R-APC-Cy5.5)-100ul
¥2980
AER61 Rabbit pAb, APC conjugated(bs-9096R-APC)-100ul
¥2980
phospho-MEK1 (Thr286) Rabbit pAb(bs-3269R)-50ul/100ul/200ul
¥1180
SRD5A1 Rabbit pAb(bs-11308R)-50ul/100ul/200ul
¥1180
CRCP Rabbit pAb, AP conjugated(bs-14048R-AP)-100ul
¥2980
万千商家帮你免费找货
0 人在求购买到急需产品
- 详细信息
- 文献和实验
- 技术资料
- 应用范围:
产品信息以Bioss网站为准
- 规格:
50ul/100ul/200ul
| 规格: | 50ul | 产品价格: | ¥1180.0 |
|---|---|---|---|
| 规格: | 100ul | 产品价格: | ¥1980.0 |
| 规格: | 200ul | 产品价格: | ¥2800.0 |
| 产品编号 | bs-0271R |
| 英文名称 | HCMV pp65 Rabbit pAb |
| 中文名称 | 巨细胞病毒PP65/CMV低基质磷脂蛋白抗体 |
| 英文别名 | PP65_HCMVM; PP65_HCMVA; Cytomegalovirus pp65; 65 kDa lower matrix phosphoprotein; 65 kDa matrix phosphoprotein; 65 kDa phosphoprotein; CMV 65 kDa lower matrix phosphoprotein; CMV pp65; Cytomegalovirus 65 kDa lower matrix phosphoprotein; Cytomegalovirus pp65; HHV 5; PP65; Tegument protein pp65; Tegument protein UL83; UL83; HCMV PP65. |
| 产品应用 | IHC-P=1:100-500, IHC-F=1:100-500, IF=1:100-500 Not yet tested in other applications. |
| 交叉反应 | HCMVPP65 |
| 抗体来源 | Rabbit |
| 免疫原 | KLH conjugated synthetic peptide derived from HCMV pp65 |
| 亚型 | IgG |
| 性状 | Liquid |
| 纯化方法 | affinity purified by Protein A |
| 克隆类型 | Polyclonal |
| 理论分子量 | 65 kDa |
| 浓度 | 1mg/ml |
| 储存液 | 0.01M TBS (pH7.4) with 1% BSA, 0.02% Proclin300 and 50% Glycerol. |
| 保存条件 | Shipped at 4℃. Store at -20℃ for one year. Avoid repeated freeze/thaw cycles. |
| 注意事项 | This product as supplied is intended for research use only, not for use in human, therapeutic or diagnostic applications. |
| 应用 | 推荐稀释比例 |
| {IHC-P} | {1:100-500} |
| {IHC-F} | {1:100-500} |
| {IF} | {1:100-500} |
Antigen retrieval: citrate buffer ( 0.01M, pH 6.0 ), Boiling bathing for 15min; Block endogenous peroxidase by 3% Hydrogen peroxide for 30min; Blocking buffer (normal goat serum,C-0005) at 37℃ for 20 min;
Incubation: Anti-Cytomegalovirus pp65 Polyclonal Antibody, Unconjugated(bs-0271R) 1:200, overnight at 4°C, followed by conjugation to the secondary antibody(SP-0023) and DAB(C-0010) staining
风险提示:丁香通仅作为第三方平台,为商家信息发布提供平台空间。用户咨询产品时请注意保护个人信息及财产安全,合理判断,谨慎选购商品,商家和用户对交易行为负责。对于医疗器械类产品,请先查证核实企业经营资质和医疗器械产品注册证情况。
 文献和实验
文献和实验[IF={{ 8.5 }}] {Chao Wang. et al.tRF-AspGTC Promotes Intracranial Aneurysm Formation by Controlling TRIM29-Mediated Galectin-3 Ubiquitination.RESEARCH.2025 Jan 7:8:0574.} {Western blot} {human}
[IF={{ 4.936 }}] {Wang et al. Octreotide Protects the Mouse Retina against Ischemic Reperfusion Injury through Regulation of Antioxidation and Activation of NF-κB. (2015) Oxid.Med.Cell.Longev. 2015:970156} {WB} {Mouse}
[IF={{ 4.936 }}] {Ma M et al. LncRNA XIST mediates bovine mammary epithelial cell inflammatory response via NF‐κB/NLRP3 inflammasome pathway.(2018) Cell Prolif.} {WB} {Bovine}
[IF={{ 20.693 }}] {Hanlin He. et al. ADAM9: A regulator between HCMV infection and function of smooth muscle cells. J MED VIROL. 2022 Nov;:} {IF} {Human}
[IF={{ 2.559 }}] {Dai M et al.Pravastatin sodium attenuated TREM-1-mediated inflammation in human peripheral blood mononuclear cells.(2019)Biochem Biophys Res Commun. Jan 1;508(1):225-229.Commun.} {WB} {Human}
 技术资料
技术资料暂无技术资料 索取技术资料






